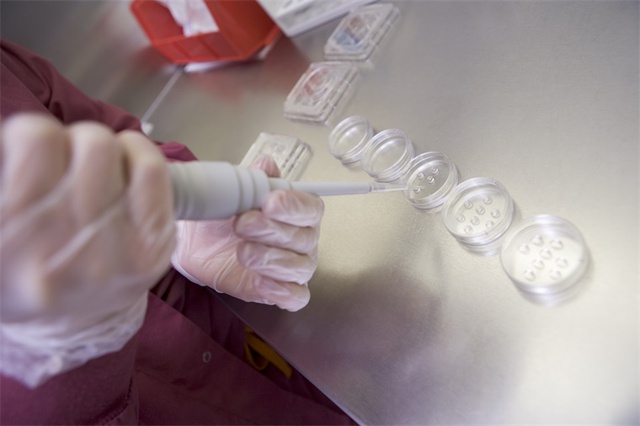

Trên toàn cầu, khoảng 250 triệu nam giới mắc chứng vô sinh, biểu hiện qua số lượng tinh trùng ít, khả năng di động kém hoặc chất lượng không tốt. Khoảng 10-15% nam giới vô sinh hoàn toàn không có tinh trùng trong tinh dịch - tình trạng gọi là vô tinh. Các cặp vợ chồng hiếm muộn thường bắt đầu thử thụ tinh trong ống nghiệm (IVF) mà chưa đánh giá yếu tố nam giới, trong khi khoảng một nửa các ca thất bại có liên quan đến nguyên nhân từ phía nam.
Hiện nay, chưa có loại thuốc điều trị vô sinh nam nào được Cục Quản lý Thực phẩm và Dược phẩm Hoa Kỳ (FDA) phê duyệt. Dù tinh trùng của những bệnh nhân này gặp vấn đề ở các mức độ khác nhau hoặc hoàn toàn không thể sản sinh tinh trùng, nhiều người trong số họ vẫn còn tế bào gốc tinh nguyên (tế bào sinh dục nguyên thủy nhất).
Công ty khởi nghiệp Mỹ Paterna Biosciences (gọi tắt là Paterna) hy vọng có thể giúp đỡ nhóm bệnh nhân này thông qua công nghệ.

Lần đầu nuôi cấy tinh trùng từ tế bào gốc trong phòng thí nghiệm
Công ty vừa công bố lần đầu tiên nuôi cấy thành công trong phòng thí nghiệm các tế bào giống tinh trùng có khả năng thụ tinh sơ bộ từ tế bào gốc tinh nguyên. Quan trọng hơn, họ còn sử dụng thụ tinh trong ống nghiệm để tạo ra phôi giai đoạn đầu có hình thái phát triển bình thường từ tinh trùng nhân tạo này, nhằm xác minh chức năng ban đầu (chưa đến giai đoạn mang thai).
Thành tựu này được coi là một bước tiến quan trọng đầy tiềm năng trong lĩnh vực nuôi cấy tinh trùng trong ống nghiệm (in vitro spermatogenesis). Nó không chỉ hứa hẹn giúp nam giới vô sinh trên toàn cầu có con cái cùng huyết thống, mà còn có thể bảo tồn khả năng sinh sản cho những bé trai phải điều trị hóa trị ung thư trước tuổi dậy thì.
Đột phá kỹ thuật: Mô phỏng vi môi trường
Ban đầu, phương án của Paterna là chiết xuất tinh trùng bằng cách nuôi cấy các ống sinh tinh (nơi tinh trùng trưởng thành). Tuy nhiên, sau khi quan sát và đối chiếu, họ nhận thấy đây không phải phương pháp tối ưu. Sau nhiều lần cải tiến công nghệ, họ đã chuyển sang lộ trình biệt hóa tế bào gốc tinh nguyên trong ống nghiệm, toàn bộ quá trình mất khoảng hơn hai tháng.
Phân tách: Đầu tiên, tế bào gốc tinh nguyên được tách ra từ mô tinh hoàn người.
Cảm ứng: Sau đó, chúng được cảm ứng để thực hiện quá trình giảm phân trong đĩa nuôi cấy.
Biệt hóa: Cuối cùng, chúng biệt hóa thành các tế bào sinh dục chứa bộ nhiễm sắc thể đơn bội (23 chiếc).
Nhóm nghiên cứu đã sử dụng sinh học tính toán và bản đồ gen đơn bào để dự đoán các tín hiệu phân tử then chốt trong từng bước hình thành tinh trùng, từ đó mô phỏng lại vi môi trường này trong phòng thí nghiệm. Họ cũng thử nghiệm nhiều tổ hợp phân tử khác nhau để tìm ra "công thức" tối ưu nhất giúp tế bào phát triển thành tinh trùng trưởng thành.

"Mỗi bước trong thí nghiệm đều có cơ chế kiểm soát cực kỳ nghiêm ngặt. Chúng tôi đã tìm ra các chỉ dẫn cần thiết để khiến những tế bào gốc này trưởng thành thành tinh trùng bình thường" Alexander Pastuszak, CEO kiêm đồng sáng lập Paterna, đồng thời là Phó giáo sư ngoại khoa tại Trường Y Đại học Utah, cho biết.
Nghiên cứu của Paterna chỉ ra rằng, trọng tâm có thể không nằm ở bản thân tế bào gốc, mà là do những khiếm khuyết trong vi môi trường xung quanh. Pastuszak tin rằng bằng cách mô phỏng một môi trường khỏe mạnh trong phòng thí nghiệm, họ có thể nuôi cấy được tinh trùng khỏe mạnh: "Mục tiêu của chúng tôi là nuôi cấy hàng nghìn tinh trùng từ một mẫu sinh thiết tiêu chuẩn và đạt tỷ lệ thành công cao trên hàng chục mẫu mô khác nhau".
Xác thực tính an toàn và hiệu quả
Kết quả thử nghiệm sớm cho thấy tinh trùng nhân tạo "gần như hoàn toàn giống" với tinh trùng tự nhiên. Tuy nhiên, công nghệ này hiện chưa được áp dụng để thử nghiệm mang thai. Việc Paterna tạo ra phôi sớm chỉ nhằm mục đích xác nhận xem tinh trùng nuôi cấy trong phòng thí nghiệm có hoạt tính hay không.
Công ty có kế hoạch triển khai một nghiên cứu quy mô lớn và toàn diện hơn trên các đối tượng nam giới vô sinh trong thời gian tới. Paterna sẽ lấy tinh trùng từ tinh dịch hoặc mô tinh hoàn của người tham gia, đồng thời sử dụng phương pháp mới của họ để nuôi cấy tinh trùng nhân tạo. Sau đó, họ sẽ so sánh tỷ lệ thụ tinh giữa hai nhóm để phân tích xem phôi tạo ra có bất thường về sinh lý, an toàn và di truyền hay không.

Lấp đầy khoảng trống trong điều trị
Trong nhiều thập kỷ qua, phương pháp chính để điều trị vô sinh nam là tiêm hormone hCG và tiêm tinh trùng vào bào tương trứng (ICSI). Nhưng điều kiện tiên quyết là hệ thống nội tiết của nam giới phải bình thường và phải có tinh trùng hiện hữu. Đối với những người mắc chứng vô tinh không do tắc nghẽn hoặc có số lượng/chất lượng tinh trùng quá kém, hiện vẫn thiếu một con đường sinh học đáng tin cậy để làm cha.
Một phương án khác là phẫu thuật tìm tinh trùng trong mô tinh hoàn. Tuy nhiên, rủi ro là ca phẫu thuật kéo dài nhiều giờ, cần gây mê toàn thân và trong một số trường hợp vẫn không thể tìm thấy tinh trùng.
Các nhà khoa học đã miệt mài tìm kiếm con đường nuôi cấy tinh trùng trong ống nghiệm suốt nhiều thập kỷ:
Năm 2011, nhóm của Giáo sư Takehiko Ogawa tại Đại học Thành phố Yokohama (Nhật Bản) lần đầu tiên nuôi cấy thành công tinh trùng chuột có khả năng sống sót. Tuy nhiên, từ chuột sang người là một thách thức khổng lồ.
Năm 2015, Công ty công nghệ sinh học Pháp Kallistem tuyên bố nuôi cấy được tinh trùng người, nhưng ngay sau đó đã bị giới nghiên cứu nghi ngờ về việc liệu tinh trùng đó đã phát triển hoàn thiện hay chưa. Mặt khác, công ty này cũng không đưa ra được bằng chứng về việc tinh trùng đó có thể thụ tinh cho trứng.
Triển vọng thị trường và rào cản
Theo thông tin công khai, Paterna đã huy động được 6 triệu USD trong vòng hạt giống (Seed round) vào năm 2024. Công nghệ của họ nhằm mục đích thay thế quy trình nuôi cấy tinh trùng truyền thống, tích hợp trực tiếp vào quy trình IVF hiện có. Sau khi sinh thiết một lượng nhỏ mô tinh hoàn tại phòng khám, mẫu sẽ được gửi đến Paterna để nuôi cấy.
Theo kế hoạch, sớm nhất là vào năm 2027, Paterna có thể bắt đầu các thử nghiệm mang thai bằng tinh trùng nhân tạo, với mức giá dịch vụ dao động từ 5.000 đến 12.000 USD.
Nếu công nghệ này tiến tới lâm sàng thuận lợi, nó không chỉ là một bước đột phá y học mà còn tái cấu trúc lại logic công nghệ của thị trường IVF. Tuy nhiên, cần lưu ý rằng nghiên cứu của Paterna vẫn đang ở giai đoạn đầu, các kết quả chưa được công bố trên các tạp chí bình duyệt và cần được xác thực độc lập. Trong tương lai, để ứng dụng lâm sàng, công nghệ này cần trải qua các bài kiểm tra nghiêm ngặt về di truyền, phát triển, độ an toàn, cũng như các đánh giá về đạo đức và phê duyệt của cơ quan quản lý.





